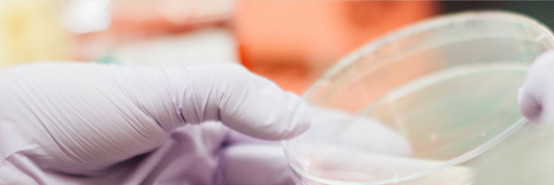

2019年福贝旗下自有品牌爱倍发布“新爱倍”品牌战略,其中包含全新的品牌价值体系、产品规划等,同时,根据战略调整后的新品胃健康系列也惊艳亮相。此次推出的胃健康系列产品,以碱性食材与肠道益生菌为核心,有效缓解爱宠胃酸过多的症状,轻松消化,保护胃健康,调理肠道,提高营养吸收。

目前,中国宠物消费已逐渐形成趋势,同时也展现了巨大的潜力,但随着宠物量的激增,宠物食品安全问题也越来越突出。近年来,因宠物食品质量问题引发的宠物生病甚至死亡事件屡见不鲜。
作为福贝旗下的自有品牌,爱倍始终秉承着将宠物食品的安全与健康放在首位,此次的胃健康系列产品获得“小鱼亲测”最高安全评级“绿鱼勋章”, 获得专业检测机构认可的背后,是爱倍对宠物食品安全的一贯坚持。

“小鱼亲测”采用的鱼胚胎生物测试技术,通过转基因鲭鳉鱼胚胎检测慢性有毒物质,通过与人类致病基因达到84%相似度的斑马鱼胚胎检测急性有毒物质,全面排查超过1000种有毒物质及其混合后的“鸡尾酒”效应,包括农药、兽药、抗生素、激素、塑化剂、有机持续污染物等,从而精确检测出食品当中对人体有影响的有毒物质,对比多个国家和地区的食品安全法规,对成分筛查演算,最终将产品检测的安全属性分为三类结果:绿鱼、黄鱼、红鱼。绿鱼代表“品质卓越”,消费者可以安心选购;黄鱼代表“基本合格”,消费者选购时需要审慎;红鱼代表“有待改善”,建议消费者购买时特别谨慎。而爱倍此次获得的“绿鱼勋章”代表安全评级最高。

爱倍以福贝品牌为依托,从起初的产品研发,到技术生产,再到食品的储存与运输,都严格遵循最高安全标准,层层把控细节,确保了福贝及爱倍严格的品质控制,用父母般的心,关爱宠物宝贝的饮食安全,营造健康的喂养环境。

爱倍此次获得小鱼亲测的“绿鱼勋章”是国产宠物食品品质实力不断提升的集中体现,也是爱倍品牌全新出发的源点,爱倍希望此次的品牌升级,不仅仅给到客户给到消费者的是品牌视觉上的升级,更多的是品牌实力及产品品质上的一次突破。
(责任编辑:admin)



